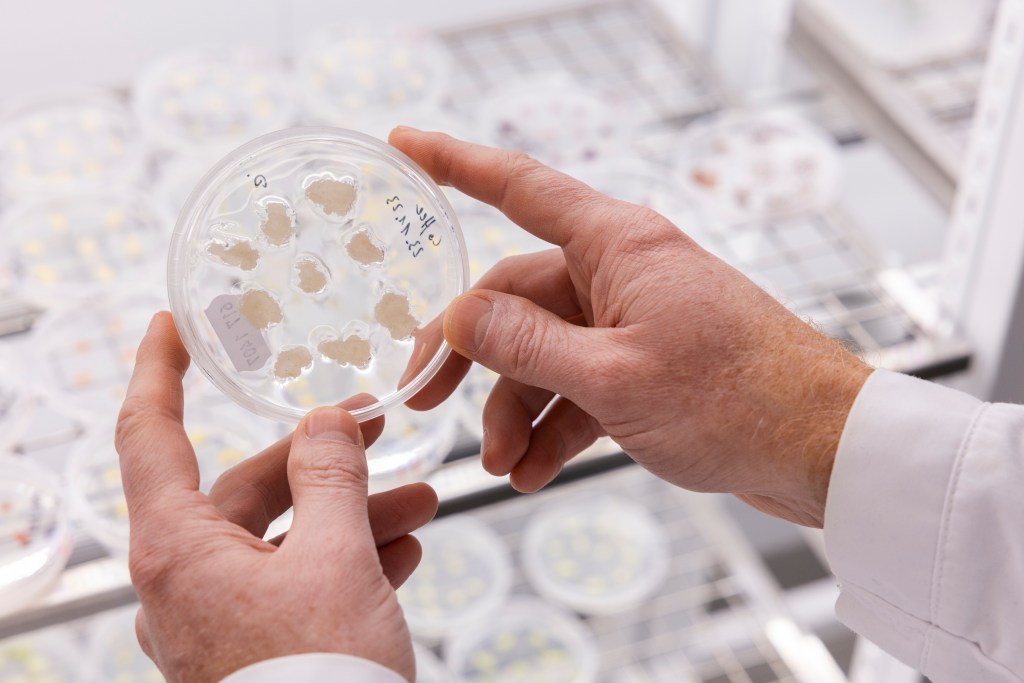

Een recent gepubliceerd onderzoek heeft laten zien hoe wetenschappers erin zijn geslaagd om koffie te maken in een laboratorium, een spannende ontwikkeling die een grote stap zou kunnen betekenen voor de toekomst van koffieproductie. In een artikel gepubliceerd in het Journal of Agriculture and Food Chemistry, beschrijven de onderzoekers het proces van het maken van koffie vanuit cellen die in een laboratorium zijn gegroeid.
Deze doorbraak komt op een moment dat de wereldwijde vraag naar koffie blijft stijgen, terwijl traditionele koffieproductiemethoden tegen hun grenzen aanlopen vanwege duurzaamheidsproblemen en klimaatverandering. Door koffie te kweken in een laboratorium, kunnen wetenschappers mogelijk bijdragen aan een duurzamere koffieproductie, met minder impact op het milieu en met meer controle over de kwaliteit van de koffie.
Het proces van laboratoriumgekweekte koffie biedt ook mogelijkheden voor een snellere productie. In plaats van te wachten op seizoensgebonden oogsten, kan laboratoriumgekweekte koffie in een veel kortere tijdspanne worden geproduceerd, waardoor de koffie-industrie flexibeler en veerkrachtiger wordt.
Hoewel deze ontwikkeling veelbelovend is, zijn er nog steeds veel uitdagingen te overwinnen voordat laboratoriumgekweekte koffie op grote schaal beschikbaar zal zijn. Het opschalen van de productie en het creëren van een volledig nieuwe koffie-industrie vergt tijd en samenwerking tussen wetenschappers, producenten en consumenten.
Desalniettemin biedt deze doorbraak hoop voor een toekomst waarin koffie op een meer duurzame en gecontroleerde manier kan worden geproduceerd, en waarin de wereld kan blijven genieten van dit geliefde drankje zonder de planeet te schaden.
Zou jij deze koffie willen proberen? Ik ben zelf wel erg nieuwsgierig, na gekweekt vlees is dit een mogelijke goede stap in de richting van een duurzamere wereld.
Copyright bovenste afbeelding: Heiko Rischer (Research Team Leader, Plant biotechnology, VTT) and coffee plants in greenhouse – Photo by Vesa Kippola

Meer informatie, klik hier
- Journal of Agricultural and Food Chemistry: Proof of concept for cell culture-based coffee
- Centre for the Promotion of Imports: What is the demand for coffee on the European market?
- VTT’s 2021 announcement: Sustainable coffee grown in Finland – the land that drinks the most coffee per capita produces its first tasty cup with cellular agriculture
